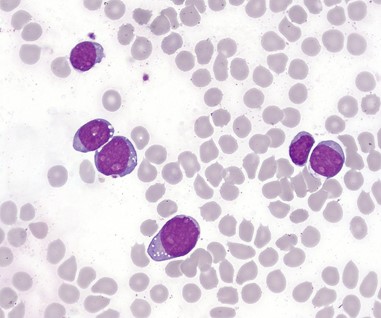
T-lymphoblastic cells of acute leukemia in the bone marrow.

Product List Background CCRF-CEM Aptamer Analysis
Background
Creative Biolabs provides a wide range of high-quality antibodies, assay kits, and CCRF-CEM proteins to help researchers improve their experiments and research. Our dedication to quality ensures reliable results, empowering researchers to produce publication-grade data.
Introduction
CCRF-CEM represents a cell line of human leukemia that originates from the peripheral blood of a patient with acute lymphoblastic. The cells were first obtained from the peripheral blood leukocytes of a four-year-old white female patient with acute lymphoblastic leukemia in November 1964. This cell line can be used for immuno-oncology and immunology research.
Acute Lymphoblastic Leukemia
ALL (Acute lymphoblastic leukemia) is a cancerous condition that develops from the uncontrolled growth of B cells or T cells of lymphocytes in the bone marrow. In the bone marrow, primitive cells that are abnormally proliferating can accumulate and inhibit normal hematopoietic function. They can also invade tissues outside the bone marrow, such as meninges, lymph nodes, gonads, liver, etc. It is reported that the occurrence of leukemia is notably higher in oil fields and polluted areas. ALL is most commonly diagnosed in children aged 0-9, representing over 70% of childhood leukemia cases. Around 20% of leukemia cases in adults are attributed to ALL.
 Fig.1 T-lymphoblastic cells of ALL.Distributed under CC BY-SA 4.0, from Wiki, without modification.
Fig.1 T-lymphoblastic cells of ALL.Distributed under CC BY-SA 4.0, from Wiki, without modification.
The treatment of ALL is to kill leukemia cells with chemical drugs, promote the proliferation of stem cells in the bone marrow that are not contaminated by leukemia cells, and replace the suppressed hematopoietic function. The treatment principle of ALL is based on its unique pathological mechanism. The disease causes a large number of cases with disordered proliferation of leukemia cells due to gene mutations. These abnormal cells cannot mature and lose normal regulation, and then invade the bone marrow and other tissues and organs. The symptoms of ALL include anemia, fever, and bleeding tendency. Anemia is caused by the massive proliferation of tumor cells, which inhibits the production of normal red blood cells; fever comes from infection because the immune system of leukemia patients is impaired; bleeding tendency is caused by leukemia cells infiltrating the blood vessel wall, leading to coagulation disorders.
As a cell line derived from an ALL patient, the CCRF-CEM cell line can be used for the study of therapeutic drugs and methods for ALL. At the same time, CCRF-CEM can also be used for research on 3D cell culture, immune system disorders, and immuno-oncology.
Creative Biolabs provides various CCRF-CEM products to help you improve your research and experiments. Our dedication to quality ensures reliable results, empowering researchers to produce publication-grade data.
CCRF-CEM Functional Service
Creative Biolabs provides anti-CCRF-CEM aptamers acclaimed for their specific binding affinity to the human CCRF-CEM cell line. These aptamers have emerged as indispensable tools in the extensive research and innovation of aptamer-based therapeutic and diagnostic approaches, particularly their potential use in targeting PTK7-positive tumor T-cell acute lymphoblastic leukemia.
 Fig.2 Evaluation of Ramos and CCRF-CEM cellular uptake of TDN and aptamer-modified TDN post-coculture via flow cytometry.1
Fig.2 Evaluation of Ramos and CCRF-CEM cellular uptake of TDN and aptamer-modified TDN post-coculture via flow cytometry.1
Researchers focused on developing a novel DNA nanostructure drug delivery system targeting PTK7-overexpressing tumour cells, specifically PTK7-positive CCRF-CEM human T-cell acute lymphoblastic leukemia. The team synthesized aptamer-modified tetrahedron DNA (s-TDN) using a one-step thermal annealing process. These anti-PTK7 aptamer-loaded complexes were used to evaluate effects on both PTK7-positive and -negative cells. In vitro studies demonstrated that the s-TDN: DOX complexes exerted specific cytotoxic effects on PTK7-positive CCRF-CEM cells, while sparing PTK7-negative Ramos cells. This targeted delivery approach highlights the potential of functionalized TDNs in treating PTK7-positive tumors.
Creative Biolabs offers specialized services aimed at the functional analysis of anti-CCRF-CEM aptamers. Customized to address the precise needs of clients, these services are vital for propelling both clinical and scientific research efforts forward.
Reference
-
Liu, Mengting, et al. "Aptamer‐targeted DNA nanostructures with doxorubicin to treat protein tyrosine kinase 7‐positive tumours." Cell Proliferation 52.1 (2019): e12511. Distributed under Open Access license CC BY 4.0, without modification.


 Datasheet
Datasheet Fig.1 T-lymphoblastic cells of ALL.
Fig.1 T-lymphoblastic cells of ALL. Fig.2 Evaluation of Ramos and CCRF-CEM cellular uptake of TDN and aptamer-modified TDN post-coculture via flow cytometry.1
Fig.2 Evaluation of Ramos and CCRF-CEM cellular uptake of TDN and aptamer-modified TDN post-coculture via flow cytometry.1
